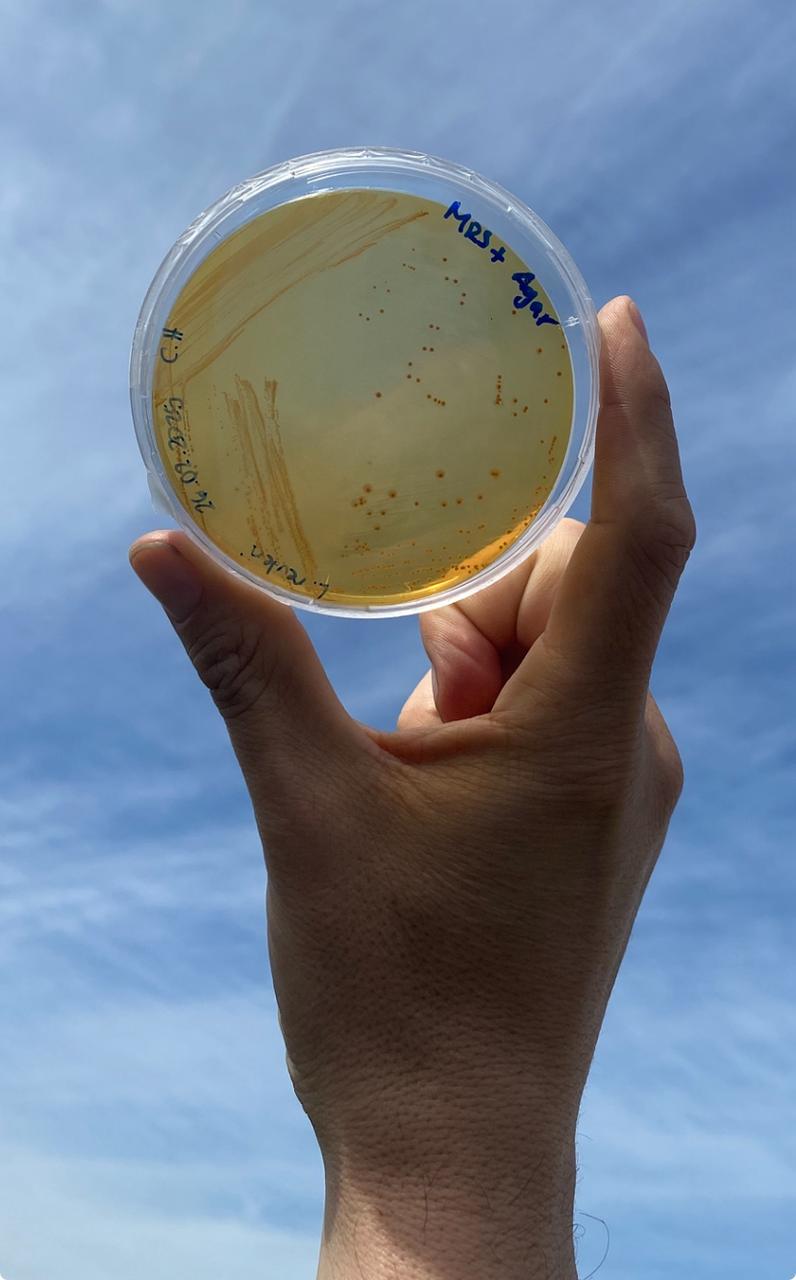

Sostenibilidad
Sostenibilidad
Científicos crean el primer envase compostable para la exportación de frutas
Investigadores de la Universidad Católica del Maule desarrollaron una alternativa para reducir el uso de plásticos en la agroexportación.
Un grupo de investigadores liderado por Rodrigo Morales Vera trabaja en un innovador desarrollo con impacto global. Se trata del proyecto BioClamshells, impulsado por la Universidad Católica del Maule (UCM), que busca sustituir los tradicionales envases plásticos para fruta —conocidos como clamshells— por una versión biodegradable, compostable y producida a partir de residuos orgánicos locales.
“El objetivo es reemplazar el clamshell convencional, derivado del petróleo, por uno biobasado, generado a partir de residuos agrícolas y orgánicos de la región del Maule”, explicó el Dr. Rodrigo Morales, director del proyecto del Fondo de Innovación para la Competitividad (FIC) y académico de la Escuela de Ingeniería en Biotecnología de la Facultad de Ciencias Agrarias y Forestales de la UCM.
Solución a una doble problemática
La iniciativa ataca dos problemáticas: el exceso de residuos agroindustriales sin destino útil y la creciente demanda de envases sustentables. Según cifras del equipo investigador, solo en la Región del Maule se generan más de 150.000 toneladas de residuos orgánicos por temporada, aunque se estima que la cifra real podría ser el doble o más.
El Gobernador del Maule, Pedro Pablo Álvarez-Salamanca Ramírez, señaló que “desde el Gobierno hemos apoyado esta iniciativa porque creemos firmemente que la innovación científica y tecnológica debe estar al servicio de nuestra gente”, dijo.
“El desarrollo de un envase compostable, confeccionado a partir de residuos locales, es un ejemplo concreto de cómo podemos mejorar la calidad de vida de los maulinos y, al mismo tiempo, proyectar nuestra región hacia el mundo. Nuestro compromiso es seguir apoyando proyectos de este tipo, que transformen problemas en oportunidades, generen desarrollo sostenible y marquen un camino de futuro para el Maule”, agregó Álvarez-Salamanca.
Estos residuos, además de generar problemas logísticos y ambientales, representan una pérdida de nutrientes para los suelos. “Lo que hacemos es tomar esos desechos — especialmente pomasa de manzana y residuos frutales—, extraer sus azúcares y fermentarlos para obtener ácido láctico”, detalló el Dr. Morales. Este ácido se polimeriza en ácido poliláctico (PLA), biopolímero base del nuevo envase.

De residuo a contenedor
El PLA se transforma en films, láminas flexibles que luego se calientan para darles forma hasta obtener la clásica estructura del clamshell, utilizada para contener frutas como arándanos, frutillas, uvas entre otros. El resultado es un envase biodegradable, compostable y con propiedades mecánicas comparables al plástico tradicional. “Sabemos que el mercado internacional, sobre todo Europa y EE.UU., es cada vez más exigente con los envases plásticos. Algunos países ya están pidiendo que sean reciclables o biodegradables. Nuestro desarrollo responde directamente a esas nuevas normativas”, destacó el Dr. Morales.
Escalabilidad y desafío
Actualmente, el equipo se encuentra en la fase de optimización del prototipo. El proceso, sin embargo, enfrenta un gran desafío: la escalabilidad. “Hoy trabajamos a nivel de laboratorio, pero producir ácido poliláctico en grandes volúmenes requiere reactores industriales que actualmente no están disponibles en Chile”, comentó el académico.
Para el director de Investigación del plantel, Dr. Ranjeeva Ranjan, la iniciativa demuestra el compromiso de la institución con la investigación aplicada y el desarrollo sostenible. “En la Universidad Católica del Maule estamos orgullosos de liderar proyectos que generan un impacto positivo, tanto a nivel local como global. Con iniciativas como BioClamshells, confirmamos que la innovación y la sostenibilidad pueden ir de la mano, respondiendo a las exigencias del mercado internacional. Este trabajo no solo busca reducir el uso de plásticos, sino también potenciar un modelo circular, que coloca a Chile en la vanguardia de la bioeconomía”, señaló.
Frente a ese panorama, la UCM apuesta a la creación de una biorrefinería local, capaz de escalar la producción a nivel nacional. “No queremos vender la licencia al extranjero; queremos que esta tecnología se desarrolle, se escale y se comercialice desde Chile”, afirmó el Dr. Morales.
El proyecto también considera la evaluación ambiental del producto mediante el análisis de ciclo de vida: huella de carbono, huella hídrica y energética, lo que permitirá ofrecer un ecoetiquetado con respaldo científico.
Validación y colaboración
La visibilidad del proyecto también ha sido estratégica. BioClamshells ha participado en múltiples eventos nacionales e internacionales, como la 5.ª Conferencia de Análisis de Ciclo de Vida de la UCM, el Congreso Internacional Bioeconomía en Colombia en la Universidad de Icesi y en diversas ferias tecnológicas, alcanzando a más de 200 beneficiarios indirectos. Este despliegue no solo ha servido para validar la propuesta ante la comunidad científica, sino también para generar redes con la industria y otros centros de investigación. El camino hacia un clamshell biodegradable 100% chileno está en marcha, con la ciencia y la sostenibilidad como motores del cambio.
Impacto local con visión global
La innovación no solo representa una alternativa más amigable con el medio ambiente, sino también una oportunidad para cerrar el ciclo de los residuos de la agroindustria local, fomentando un modelo verdaderamente circular y sostenible. “Estamos reutilizando un desecho de la región para crear un producto que puede volver a la tierra sin contaminar. El proceso es 100% local, renovable y sostenible”, concluyó el investigador.
Con el respaldo del Gobierno Regional del Maule y el compromiso del equipo científico, Bioclam Shells aspira a convertirse en una referencia nacional en innovación sostenible aplicada a la agroexportación. Y desde Talca, darle al mundo un nuevo estándar de un empaque chileno, biodegradable y hecho a partir de lo que antes simplemente era un problema.